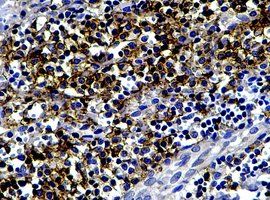
多克隆抗體 多克隆抗體

組織結構
抗原通常是由多個抗原決定簇組成的,由一種抗原決定簇刺激機體,由一個B淋巴細胞接受該抗原所產生的抗體稱之為單克隆抗體(Monclone antibody)。由多種抗原決定簇刺激機體,相應地就產生各種各樣的單克隆抗體,這些單克隆抗體混雜在一起就是多克隆抗體,機體內所產生的抗體就是多克隆抗體;除了抗原決定簇的多樣性以外,同樣一種抗原決定簇,也可刺激機體產生IgG、IgM、IgA、IgE和IgD等五類抗體。
抗原上那部分可以引起機體產生抗體的分子結構,叫做抗原決定簇。一個抗原上可以有好幾個不同的抗原決定簇,因而使機體產生好幾種不同的抗體,最終產生出抗體是漿細胞。只針對一個抗原決定簇起作用的漿細胞群就是一個純系,純系的英文為Clone,音譯就是克隆。由一種克隆產生的特異性抗體叫做單克隆抗體。單克隆抗體能目標明確地與單一的特異抗原決定簇結合,就象飛彈精確地命中目標一樣。另一方面,即使是同一種抗原決定簇,在機體內也可以由好幾種克隆來產生抗體,形成好幾種單克隆抗體混雜物,稱為多克隆抗體。
多克隆抗體又簡稱多抗。與之相對應的叫單克隆抗體,簡稱單抗。
抗體分類
抗原通常是由多個抗原決定簇組成的,由一種抗原決定簇刺激機體,由一個B淋巴細胞接受該抗原所產生的抗體稱之為單克隆抗體(Monoclone antibody)。由多種抗原決定簇刺激機體,相應地就產生各種各樣的單克隆抗體,這些單克隆抗體混雜在一起就是多克隆抗體,機體內所產生的抗體就是多克隆抗體;除了抗原決定簇的多樣性以外,同樣一類抗原決定簇,也可刺激機體產生IgG、IgM、IgA、IgE和IgD等五類抗體。多克隆抗體是由異源抗原(大分子抗原、半抗原偶聯物)刺激機體產生免疫反應,有機體漿細胞分泌的一組免疫球蛋白。多克隆抗體由於其可識別多個抗原表位、可引起沉澱反應,製備時間短,成本低的原因廣泛套用於研究和診斷方面。
抗原準備
概述
可以作為抗原的物質有很多種,一般的科研實驗中,經常使用的抗原有:偶聯多肽、偶聯的小分子或化合物、天然或重組蛋白等等。
對可溶性抗原而言,為了增強其免疫原性或改變免疫反應的類型、節約抗原等目的,常採用加佐劑的方法以刺激機體產生較強的免疫應答。
佐劑套用
1.佐劑的類型 目前實踐中常套用的佐劑有氫氧化鋁膠、明礬、弗氏佐劑、脂質體和石蠟
油等。也有採用結合桿菌等分枝桿菌、白喉桿菌以及細小棒狀桿菌等。
⑴ 弗氏不完全佐劑(incomplete Freund's adjuvant,IFA)
羊毛脂 1 份
石蠟油 5 份
混合,高壓滅菌後保存。用時加熱融化,冷卻至 50℃左右,加抗原進行乳化處理。
⑵ 弗氏完全佐劑(complete Freund's adjuvant,CFA)
弗氏不完全佐劑 10ml
卡介苗 10mg~200mg 卡介苗可 100℃10min 滅活處理。
初次免疫時,最好用弗氏完全佐劑,以刺激機體產生較強的免疫反應。再次免疫時,一般不用完全佐劑,而採用弗氏不完全佐劑。但在研究分枝桿菌及相關抗原時,一般不用弗氏完全佐劑,以免卡介苗的干擾。
⑶ 脂質體:是人工製備的類脂質的小球體,由一個或多個酷似細胞膜的類脂雙分子層組成,這種結構使其能夠攜帶各種親水的、疏水的和兩性物質,他們被包裹在脂質體內部的水相中,或插入類脂雙分子層或吸附、聯接在脂質體的表面,起到明顯的免疫增強作用。
⑷ 油佐劑 :採用植物油和礦物油均可,包括豆油、花生油、油菜油等。目前套用最廣的礦物油。 10 號 白油(石蠟油) 100ml
硬脂酸鋁 2g
司本 80 6ml
混合加熱融化,分裝。用時按下列配方進行乳化。
油相 3 份
水相(加 4%吐溫-80) 1 份
先把油相攪拌起來,然後緩慢加入水相乳化。司本是油分散劑,吐溫是水分散劑,均有利於
乳化。
乳化作用
將抗原與佐劑混合的過程稱為乳化。乳化的方法很多,可採用研缽乳化;可直接在鏇渦振盪器上乳化;可用組織搗碎器乳化。少量時,特別是弗氏佐劑與抗原乳化時,常採用注射器乳化,用兩個注射器,一個吸入抗原液,一個吸入佐劑,兩注射器頭以膠管連線,注意一定紮緊,然後來回抽吸。當大量乳化時,可採用膠體磨進行。
乳化好的標誌是取一滴乳化劑滴入水中呈現球形而不分散。如出現平展擴散即為未乳化好。乳化過的物質放置一段時間(在保存期內)出現油水分層也是未乳化好的表現。 根據抗原的性質、免疫原性和動物的免疫反應性來決定免疫途徑、免疫次數和間隔時間等。 免疫途徑包括皮下注射、皮內注射、肌肉注射、靜脈注射、腹腔注射以及淋巴結內注射等。抗原量少,則一般多採用加佐劑,淋巴結內或淋巴結周圍、或足掌、或皮內、皮下多點注射,如抗原量多,則可採用皮下、肌肉、以至靜脈注射。 注射間隔時間 帶佐劑的皮內、皮下注射,一般為間隔 2~4 周免疫一次。不帶佐劑的皮下或肌肉注射,一般為 1~2 周間隔時間;肌肉或靜脈免疫的,可 5 天左右的間隔時間。 可以把各種注射途徑聯合起來套用,最終以達到效價要求為目的。
免疫動物
供免疫用的動物主要是哺乳動物和禽類,常選擇家兔、綿羊、山羊、馬、騾和豚鼠及小鼠等。動物的選擇常根據抗體的用途和量來決定,也與抗原的性質有關。如要獲得大量的抗體,多採用大動物;如要是獲得直接標記診斷的抗體,則直接採用本動物;如要獲得間接的標記診斷用抗體,則必須用異源動物製備抗體;如果難以獲得的抗原,且抗體的需要量少,則可以採用純系小鼠製備;一般實驗室採用的抗體,多用兔和羊製備。
免疫用的動物最好選擇適齡的健康雄性動物,雌性動物特別是妊娠動物用於製備免疫抗體則非常不合適,有時甚至不產生抗體。由於對免疫應答的個別差異,免疫時應同時選用數隻動物進行免疫。 抗原是多種多樣的,而且千差萬別。就其化學成分而言,有蛋白質抗原、類脂抗原、多糖類抗原和核酸抗原等。就抗原性而言,有完全抗原和不完全抗原。為了獲得較好的抗血清,最好是選用蛋白質抗原,如要製備用於篩選細菌表達的 cDNA 文庫或免疫印跡的抗血清,最好選用可降解的蛋白質抗原。不同的抗原,其免疫原性的強弱均不相同,這種免疫原性的強弱取決於抗原的分子量、化學活性基團、立體結構、物理形狀和彌散速度等。
抗原的免疫劑量是依照給予動物的種類、免疫周期以及所要求的抗體特性等不同而不同。劑量過低,不能引起足夠強的免疫刺激,免疫劑量過多,有可能引起免疫耐受。在一定的範圍內,抗體的效價是隨注射劑量的增加而增高。蛋白質抗原的免疫劑量比多糖類抗原寬。一般而言,小鼠的首次免疫劑量為 50μg~400μg/次, 大鼠為100μg~1 000μg/次, 兔為 200μg~1 000μg/2次。加強劑量為首次劑量的 1/5~2/5。
免疫劑量與注射途徑有關,一般而言,靜脈注射劑量大於皮下注射,而皮下注射又比掌內和跖內皮下注射劑量大,也可採用淋巴結內注射法。加佐劑比不加佐劑的注射劑量要小,對家兔而言,採用弗氏完全佐劑,則需注射 0.5mg~1mg/kg./次,如採用弗氏不完全佐劑則注射劑量應大10 倍以上。如要製備高度特異性的抗血清,可選用低劑量抗原短程免疫法。如需要獲得高效價的抗血清,宜採用大劑量長程免疫法。免疫周期長者,可少量多次。免疫周期短者,應大量少次。 兩次注射的間隔時間應長短適宜,太短起不到再次反應的效果太長則失去了前一次激發的敏感作用。一般間隔時間應為 5~7 天,加佐劑者應為 2 周左右。 注射的 Ig 純度高,則一般不易引起過敏反應,如注射血清,即使是少量,在再次免疫時,極易引起過敏反應,所以一定要採取措施。
抗體鑑定
抗體的效價鑑定 不管是用於診斷還是用於治療,製備抗體的目的都是要求較高效價。不同的抗原製備的抗體,要求的效價不一。鑑定效價的方法很多,包括有試管凝集反應、瓊脂擴散試驗、酶聯免疫吸附試驗9ELISA)等。常用的抗原所製備的抗體一般都有約成的鑑定效價的方法,以資比較。如製備抗抗體的效價,一般就採用瓊脂擴散試驗來鑑定。
抗體的特異性鑑定 抗體的特異性是指與相應抗原或近似抗原物質的識別能力。抗體的特異性高,它的識別能力就強。衡量特異性通常以交叉反應率來表示。交叉反應率可用競爭抑制試驗測定。以不同濃度抗原和近似抗原分別做競爭抑制曲線,計算各自的結合率,求出各自在 IC50時的濃度,並按下列公式計算交叉反應率。 如果所用抗原濃度IC50濃度為pg/管,而一些近似抗原物質的IC50濃度幾乎是無窮大時,表示 這一抗血清與其他抗原物質的交叉反應率近似為 0,即該血清的特異性較好。
抗體的親和力 是指抗體和抗原結合的牢固程度。親和力的高低是由抗原分子的大小、抗體分子的結合位點與抗原決定簇之間立體構型的合適度決定的。有助於維持抗原抗體複合物穩定的分子間力有氫鍵、疏水鍵、側鏈相反電荷基因的庫侖力、范德華力和空間斥力。親和力常以親和常數K表示,K的單位是L/mol,通常K的範圍在 108 ~1010 /mol,也有多達 1014 /mol。抗體親和力的測定對抗體的篩選,確定抗體的用途,驗證抗體的均一性等均有重要意義。
抗血清凍存
抗血清收穫後,加 1/萬硫柳汞或 1/萬的疊氮鈉防腐,或加入等量的中性甘油,分裝小瓶,置-20℃以下的低溫保存,數月至數年內抗體效價無明顯變化。注意避免反覆凍融。也可將抗血
清冷凍乾燥後保存。
抗Ig抗體製備
多克隆抗體的製備一般包括以下幾個步驟:
1、製備抗原。
2、選擇實驗動物。
3、動物免疫。
4、試取血進行測試,看看是否成功免疫。
5、如果成功免疫,殺死實驗動物,採集全部血清。
6、純化出抗體。
7、鑑定抗體。包括純度以及特異性。
具體操作與製備原理參見中國免疫學實驗網。
(一)抗原製備
Ig 是免疫球蛋白,對異種動物而言,是良好的抗原物質。可以刺激異種動物產生抗 Ig 血清,
經適當提取後,產生抗 Ig 抗體,又叫第二抗體或抗抗體。在多數的間接標記反應中,均需製備
抗 Ig 抗體。
(二)材料與試劑
1.提取的動物 Ig
2.弗氏完全佐劑和弗氏不完全佐劑
3.青黴素和鏈黴素
4.實驗動物 兔
5.其它材料及試劑
操作方法
免疫方法
可以採用以下各種方法之一進行免疫。
(1)淋巴結注射法:①在兔的兩後足跖部皮下(或皮內)注射活卡介苗 50mg(每側約0.30ml) 。7~10 天后,兔跖及膕肌淋巴結腫大;②於腫大的兩側淋巴結內各注射加有完全佐劑的IgG 乳化抗原 0.50ml(含 IgG 5mg/ml、青黴素 1 000U/ml、鏈黴素 1 000μg/ml);③必要時,14 天后,重複步驟②一次;④再過 7 天后,於兩側淋巴結內各注射加有完全佐劑的 IgG 乳化抗原0.50ml(含IgG5mg/ml、青黴素 1 000U/ml、鏈黴素 1 000μg/ml) ;⑤5~7天后,耳靜脈採血。測定血清效價。
(2)皮下多點注射法:①家兔兩側掌(跖內各注射含有完全佐劑抗原 0.10ml(IgG 含量5mg/ml) ;②7~10 天后,脊柱兩側多點(頸、胸、腰椎各兩點、共 6 點)皮下注射含不完全佐劑5的抗原,每點 0.50ml;③7~10 天后,脊柱兩側重複注射一次;④7~10 天后試血。不合格者重複步驟③。
(3)多途徑聯合注射法:①兩側掌(跖)內側皮下注射含完全佐劑抗原 0.50ml(IgG 量為 5mg/ml) ;②14 天后,多點皮下注射含有不完全佐劑抗原;③7 天后,耳靜脈注射不含佐劑的抗原 2ml;④測定血清抗體效價,不合格者重複步驟③,並適當遞增 IgG 量。
效價測定
採用瓊脂擴散法。
⑴ 將血清倍比稀釋,加入外周孔。
⑵ 中間孔加動物 Ig。
⑶ 37℃濕盒瓊擴 24 小時,觀察結果。
免疫系統
| 系統 | 自適應與天然 | 體液與細胞 | 補體(過敏毒素) | 固有 |
| 抗原與抗體 | 抗原 (超抗原;變應原) | 半抗原 |
| 表位 (線性;構象) | |
| 抗體 (單克隆抗體; 多克隆抗體;自身抗體) | 多克隆B細胞反應 | 同種異型 | 同種型 | 遺傳型 | |
| 免疫複合物 | |
| 免疫細胞/白細胞 | 淋巴系細胞: T細胞 | B細胞 | NK細胞 |
| 髓系細胞:肥大細胞 | 嗜鹼性粒細胞 | 嗜酸性粒細胞 | 巨噬細胞 | |
| 吞噬細胞:中性粒細胞 | 巨噬細胞/網狀內皮系統 | |
| 專職型 APCs:樹突狀細胞 | 巨噬細胞 | B細胞 | |
| 免疫與耐受 | 作用:免疫性 | 自身免疫 | 變態反應 | 炎症 | 交叉反應性 |
| 無作用:耐受 (中樞耐受;外周耐受;克隆無能;克隆缺失) | 免疫缺損 | |
| 免疫遺傳學 | 體細胞超突變 | V(D)J 重組 | 免疫球蛋白類別轉換 | MHC/HLA |
| 免疫物質 | 細胞因子 | 調理素 | 溶細胞素 |
| 其他 | 診斷免疫學 |
免疫系統/ 免疫學
| 免疫系統 | 它是人體抵禦病原菌侵犯最重要的保衛系統。 |
| 系統 | |
| 抗原與抗體 | 抗原 (超抗原, 變應原) | 半抗原 表位 (線性表位, 構象表位) 抗體 (單克隆抗體, 多克隆抗體, 自身抗體) | 多克隆B細胞反應 | 同種異型 | 免疫球蛋白同種異型 | 遺傳型 | 免疫複合物 |
| 免疫細胞/白細胞 | 淋巴系細胞:T細胞 | B細胞 | NK細胞 髓系細胞:肥大細胞 | 嗜鹼性粒細胞 | 嗜酸性粒細胞 | 巨噬細胞 吞噬細胞:中性粒細胞 | 巨噬細胞 | 網狀內皮系統 抗原遞呈細胞:樹突狀細胞 | 巨噬細胞 | B細胞 |
| 免疫 與 耐受 | 作用:免疫性 | 自身免疫 | 變態反應 | 炎症 | 交叉反應性 無作用:耐受 (中樞耐受, 外周耐受, 克隆無能, 克隆缺失) | 免疫缺損 |
| 免疫遺傳學 | 體細胞超突變 | V(D)J 重組 | 免疫球蛋白類別轉換 | MHC/HLA |
| 免疫物質 | 細胞因子 | 調理素 | 溶細胞素 |
| 其他 | 診斷免疫學 |